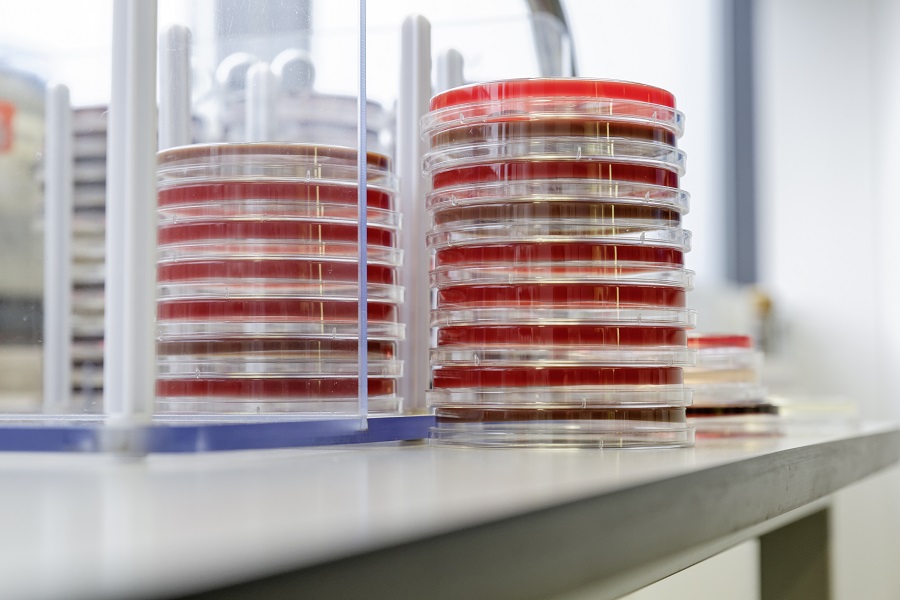
Petrischalen stehen gestapelt auf einer Fensterbank.

Die HELP-App soll Behandelnde beim zielgerichteten Einsatz von Antibiotika in Kliniken helfen. So trägt sie auch dazu bei, die Ausbildung gefährlicher Resistenzen zu verringern. Die App wurde in dem vom BMBF geförderten SMITH-Konsortium entwickelt.
Fünf deutsche Universitätsklinika – Aachen, Essen, Halle, Jena und Leipzig – erproben den Einsatz der HELP-App im klinischen Alltag.
UKJ/Schroll
Staphylokokken sind eine der häufigsten Ursachen von Blutstrominfektionen, die zu lebensbedrohlichen Komplikationen führen können. Patientinnen und Patienten gezielt und wirkungsvoll zu behandeln und dabei insbesondere auf eine verantwortungsvolle Antibiotikatherapie zu achten – das ist das Ziel der HELP-App: „Hospital-wide ELectronic Medical Record Evaluated Computerised Decision Support System to Improve Outcomes of Patients With Staphylococcal Bloodstream Infection“. Die App wurde unter Federführung des Universitätsklinikums Jena entwickelt. Seit Ende Juni 2021 erproben die Universitätskliniken Aachen, Essen, Halle, Jena und Leipzig die mobile Anwendung im klinischen Alltag, um die Versorgung zu verbessern.
„Als digitales Handbuch informiert die App die behandelnden Ärztinnen und Ärzte auf Normal- und Intensivstationen über die jeweils nächsten diagnostischen und therapeutischen Schritte“, sagt Prof. Dr. André Scherag, Direktor des Instituts für Medizinische Statistik, Informatik und Datenwissenschaften am Universitätsklinikum Jena und einer der SMITH-Sprecher. „Wir möchten so die Patientenversorgung unmittelbar verbessern. Aus diesem Grund evaluieren wir die App mit einer klinischen Studie, die in die Krankenversorgung eingebettet ist.“
Fünf deutsche Universitätsklinika sind an der HELP-Studie beteiligt
An der klinischen Studie beteiligen sich fünf deutsche Universitätsklinika: Aachen, Essen, Halle, Jena und Leipzig. Mit dem Standort Essen ist die App seit Ende Juni an allen Standorten im Einsatz. Mittlerweile können schon 54 von insgesamt 134 an der Studie beteiligte Stationen mit der HELP-App arbeiten. Es gab bereits viele positive Rückmeldungen von behandelnden Ärztinnen und Ärzten verschiedener Standorte über die übersichtliche Hilfestellung.
HELP belegt, dass die Vernetzung der Datenintegrationszentren funktioniert
Die App zeigt die Möglichkeiten moderner digitaler Dienstleistungen und Infrastrukturen im Gesundheitsbereich auf. Die an den SMITH-Standorten aufgebauten Datenintegrationszentren erschließen die für die HELP-Studie erforderlichen Daten, beispielsweise aus den mikrobiologischen Befunden, und stellen sie anonymisiert für die Studienauswertung bereit. „Die Zentren schaffen die technischen und organisatorischen Voraussetzungen für die standortübergreifende Datennutzung. Wir zeigen mit HELP, dass das auch wirklich funktioniert“, so Dr. Danny Ammon, Leiter des Datenintegrationszentrums am Universitätsklinikum Jena. Die Datenintegrationszentren sollen als nachhaltige Struktur der Medizininformatik-Initiative dafür sorgen, dass medizinischen Daten für die Verbesserung von Versorgung und Forschung nutzbar werden.
Weitere Information auf der SMITH-Homepage: Zielgerichtete Antibiotikatherapie in der Infektionsmedizin